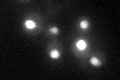
YNL182C
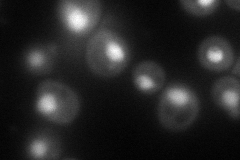
YNL182C
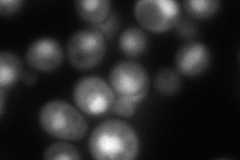
YNL182C
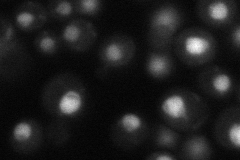
YNL182C
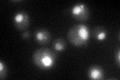
YNL182C

View description
Essential component of the Rix1 complex (Rix1p, Ipi1p, Ipi3p) that is required for processing of ITS2 sequences from 35S pre-rRNA; highly conserved and contains WD40 motifs; Rix1 complex associates with Mdn1p in pre-60S ribosomal particles
Localization:
Intensity:
Fold change:
Significance:
-
C’ GFP library in SD
nucleus52.61 -
N' NOP1pr-GFP in SD
nucleus118.699 -
N' TEF2pr-mCherry in SD
nucleus100.335 -
N' NATIVEpr-GFP in SD
nucleus50.1197 -
N' TEF2pr-VC and Cyto-VN in SD

nucleus49.5123 -
C’ GFP library in SD+DTT
nucleus38.150.72No -
C’ GFP library in SD+H2O2

nucleus50.980.96No -
C’ GFP library in Starvation Media

nucleus21.90.41Yes -
C’ GFP library on the background of Pup2-DaMP

nucleus -
C’ GFP library on the background of CCT mutant

nucleus50.84050.966192No
